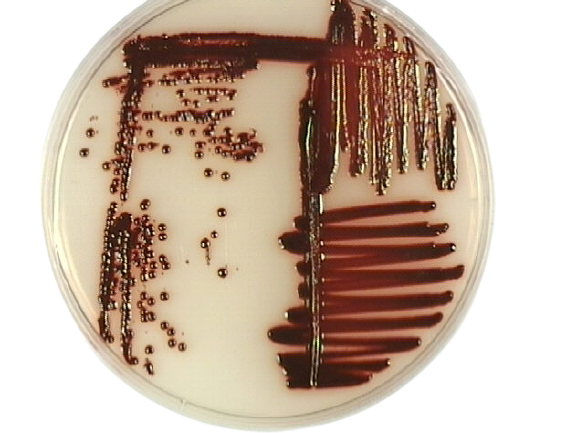
Red colonies of Serratia marcescens in Tryptic Soy Agar - Serratia marcescensgrew as bright, glossy red colonies on the TSA plate (Imagesource)

The genus Serratia currently contains >15 recognized species, seven of which have been isolated from human clinical specimens. S. marcescens is the most important member of the genus. Recognized as an important opportunistic pathogen, S. marcescens is the most frequently encountered species in clinical specimens. S. liquefaciensand S. odoriferaare sometimes found in clinical materials.

Properties
- Member of the Enterobacteriaceaefamily;
- They ferment lactose very slowly (late lactose-fermenter).
- Small motile rod having peritrichous flagella
- Some strains produce a red diffusible pigment (prodigiosin) in culture and also in various foods.
- An important cause of nosocomial infection.
Earlier,S marcescenswas considered to be non-pathogenic saprophytes and was often used as abiological markerfor studying the transmission of microorganisms.
Pathogenesis
**Source:**S. marcescensis found in tap water/shower, air conditioning units, and mostly in medical equipment such as nebulizers and bronchoscopes.
Transmission: The predominant mode of spread of S. marcescens is thought to be hand-to-hand transmission by hospital personnel.
Virulence
Biofilm formation by S. marcescens is responsible for its pathogenicity as well as drug resistance. Other probable virulence factors of S. marcescens include;
- Adherence and hydrophobicity mediated by mannose-resistant (MR) pili and mannose-sensitive (MS) pili.
- Endotoxic properties of lipopolysaccharide (LPS)
- These different enzymes produced by S. marcescens may act as virulence factors,
chitinase, lipase, chloroperoxidase and an extracellular protein, HasA.
Infection
Serratiaspecies are found mostly in soil and water. An opportunistic pathogen, Serratiacauses urinary tract infections, wound infections, and occasionally pneumonia. Septicemia, endotoxic shock, and endocarditis due to S. marcescens have also been reported. Serratiaalso causes endocarditis in users of injection drugs. Infections due to S. marcescensare on increase in recent years, particularly among hospitalized patients, causing nosocomial surgical wound infections.
Laboratory Diagnosis
**Gram stain:**Serratia species are Gram-negative rods.
| Name of the test | Result |
|---|---|
| Urease test | varies according to bacterial strains. |
| Voges-Proskauer test | Positive |
| ONPG test | Positive |
| Lactose fermentation | varies according to bacterial strains. |
| Mannitol fermentation | Positive |
| Glucose fermentation | Positive |
| Sucrose fermentation | Positive |
| Oxidase test | Negative |
| Citrate test | Positive |
| Motility | Positive |
| Indole test | Negative |
| Lysine decarboxylase | Positive |
| TSI/KIA medium* | Acid or Alkali/Acid, gas (-), H2S (-) * |
Culture: S. marcescensgrows well on blood agar and MacConkey agar. It is non-lactose fermenting. Some strains produce a red pigment in nutrient agar, tryptic soy agar, MacConkey agar at room temperature.
Identification: They are distinguished by biochemical tests from other coliforms.
Antimicrobial Sensitivity
Serratia species are often resistant to multiple antibiotics. Quorum sensing (QS) plays important role in antibiotic resistance and biofilm production among Serratia marcescens. Serratiaspecies are usually resistant to cephalosporins, polymyxins, and occasionally also to aminoglycosides.
References and further reading
- Hirakata Y. (2002). Nihon rinsho. Japanese journal of clinical medicine, 60(11), 2156–2160.
- Mahlen S. D. (2011). Serratia infections: from military experiments to current practice. Clinical microbiology reviews, 24(4), 755–791. https://doi.org/10.1128/CMR.00017-11
- Bailey & Scott’s Diagnostic Microbiology, Forbes, 11th edition
- Gupta, V., Sharma, S., Pal, K., Goyal, P., Agarwal, D., & Chander, J. (2021). Serratia, No Longer an Uncommon Opportunistic Pathogen – Case Series & Review of Literature. Infectious disorders drug targets, 21(7), e300821191666. https://doi.org/10.2174/1871526521666210222125215